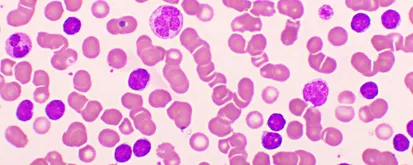
101 article: What Is CLL?

Education, community and tools to navigate your disease
Lifetime support and education
Your brighter tomorrow starts today with free patient education resources

Clinical Trials
Fusing Non-Covalent and Covalent BTK Inhibitors for CLL with Rocbrutinib
Jan 26, 2026

Core Education
February 4th is World Cancer Day
Jan 26, 2026

HealthTree Press
HealthTree Joins Centers for Medicare & Medicaid Services "Kill the Clipboard" and Conversational AI Initiatives
Jan 23, 2026
Stay up-to-date with all the latest disease news curated by what matters most
north_east
Join in-person at our expert panel roundtable events
north_east
Listen and learn from our expert guests on HealthTree Podcast
north_east
Join free online events or watch webinars with experts
north_east
Get fast and personalized support with free patient navigators
north_east
Learn with courses taught by hundreds of disease specialists
north_east
Learn more with 101 patient guides
Meaningful patient-to-patient connections
Find a community of CLL patients who care and are just like you

Powerful Patient Data Portal
HealthTree Cure Hub helps you navigate your disease by tracking your labs and so much more

You can help advance CLL research
In HealthTree Cure Hub, your data and researchers' expertise combine to shorten the breakthrough time from years to days; every second counts

Get involved today!
At HealthTree we're on a mission to accelerate cures. Here's how you can help:
Join a local chapter
Our chapters are designed to empower and activate patients and caregivers who are committed to finding a cure. In partnership with HealthTree, chapters provide support, education, and raise revenue to cure diseases
Find a community arrow_forward
Donate to HealthTree, a nonprofit organization
Our core mission is to provide as many patient resources possible to any and all underserved communities in the US and eventually worldwide.
Donate to HealthTree arrow_forward
Together we care.
Together we cure.
100% of every dollar you give supports our life-changing mission.